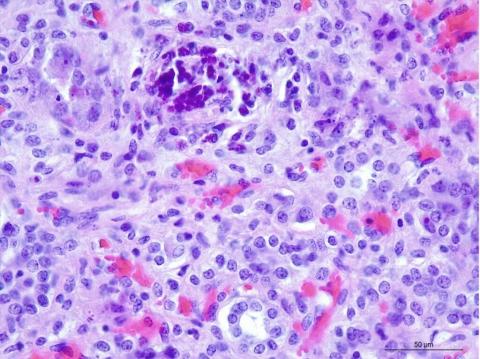

Animal: Pig, Pietrain crossbred, 15-weeks-old
Organ: Kidney
History: Kidney was submitted without case history. A quantitative PCR for porcine circovirus 2 was performed (PCV2) (1,67 x 10 EXP 14 copies/g)
Macroscopical findings: Pale kidney with cortical petechiae
Histopathological findings: Mild tubular necrosis and some of the tubules show a somewhat haphazardly arrangement, separated by small numbers of macrophages, lymphocytes and plasma cells embedded in small amounts of fibrous connective tissue. Viral botryoid inclusions were seen in macrophages and renal tubular epithelial cells. HE stain
Diagnosis: Kidney: Lymphohistiocytic interstitial nephritis, chronic, with PCV2 botryoid inclusions
Contributor: Nermin Caliskan and Han Versnaeyen, Animal health lab Flanders (DGZ Vlaanderen), BELGIUM